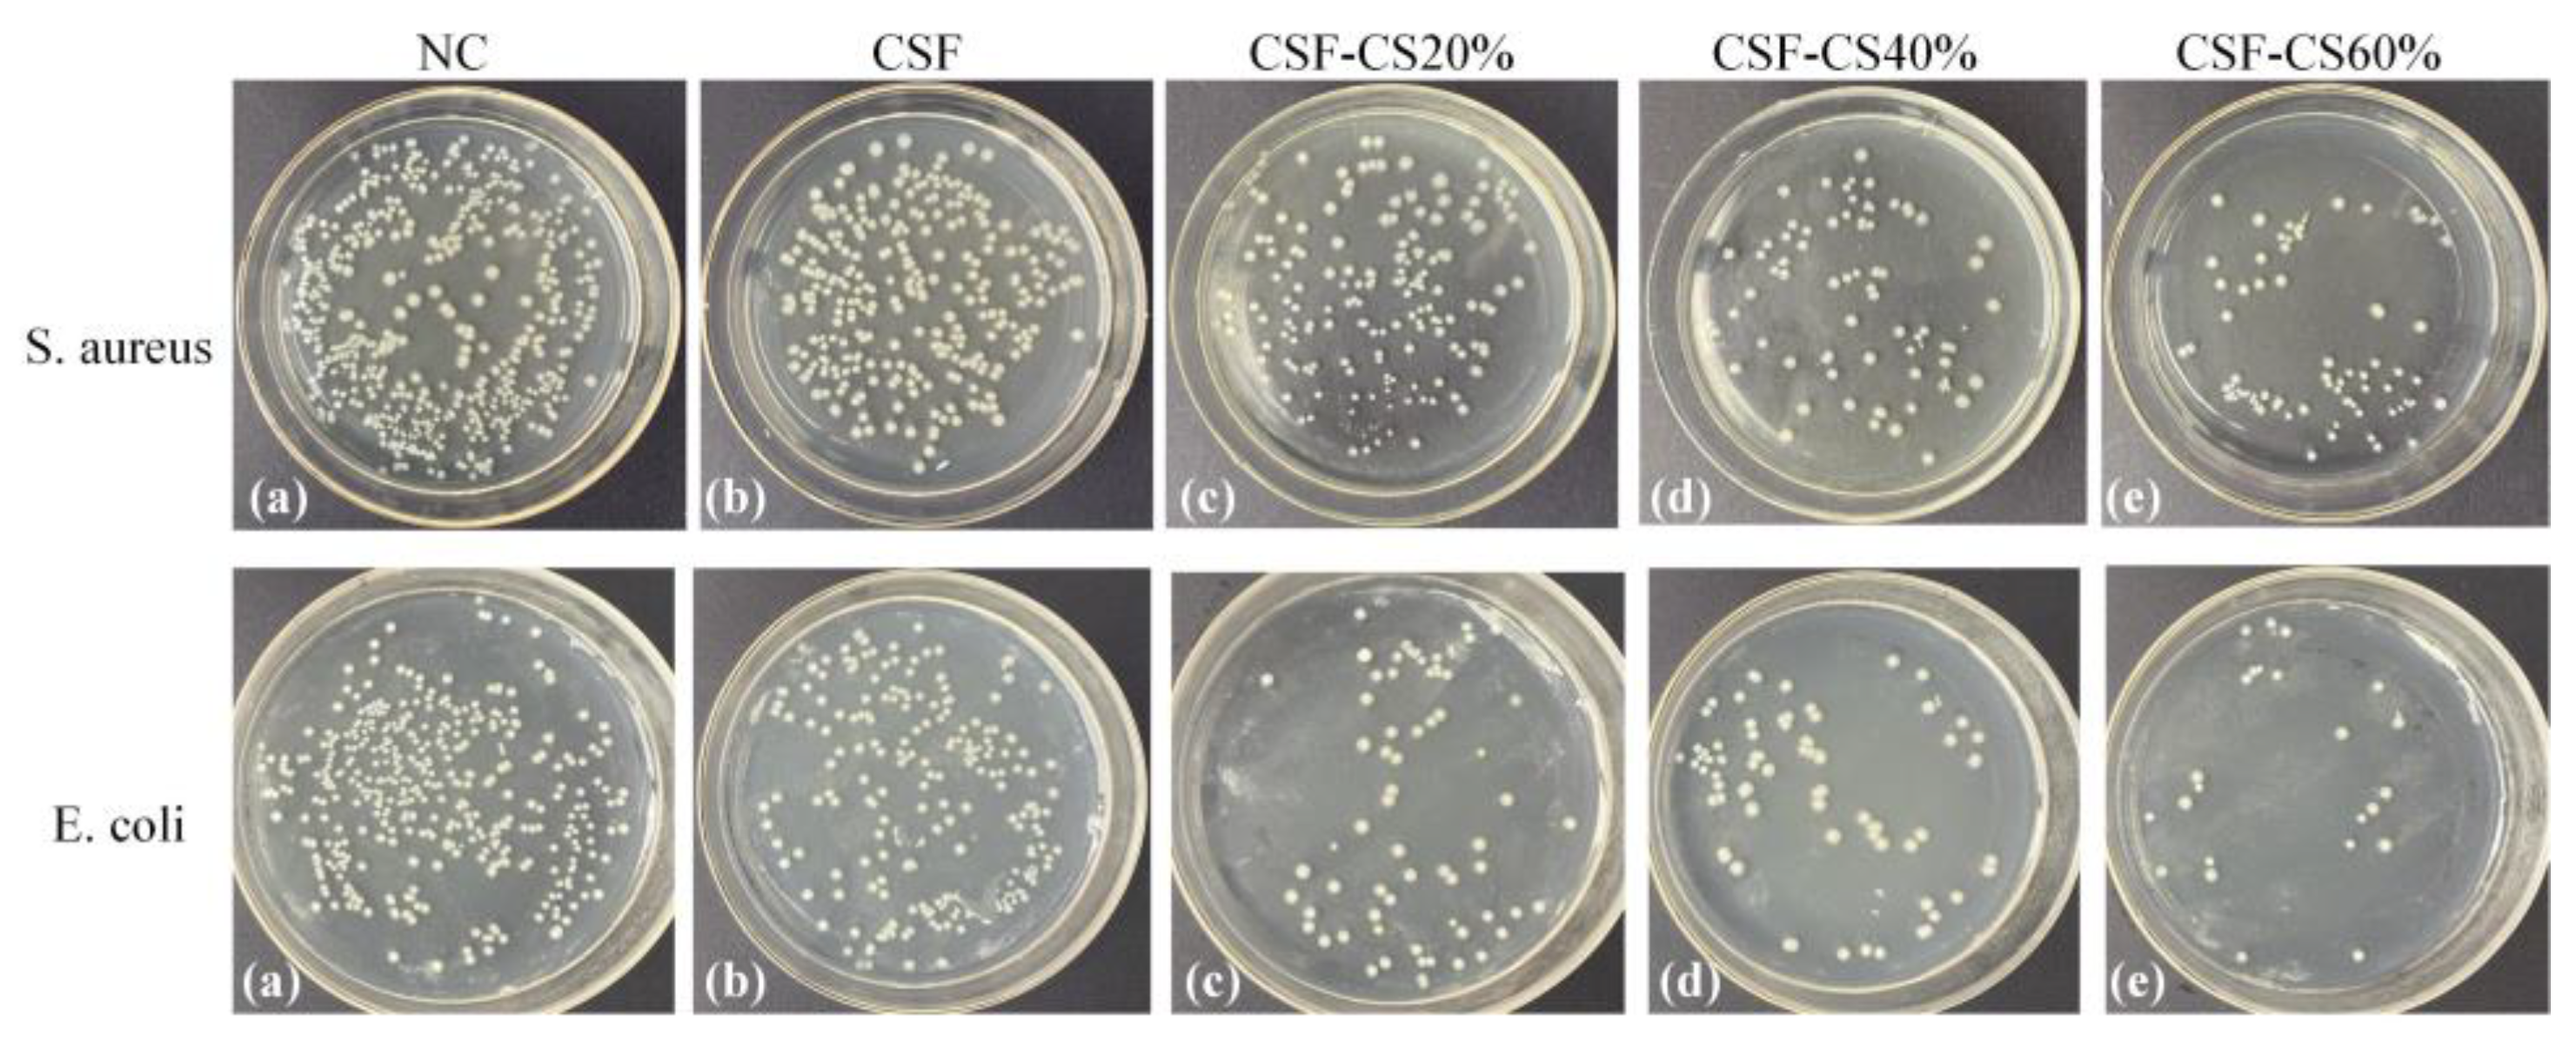
Materials 17 02986 g008

Wound Dressing Based on Cassava Silk-Chitosan
Abstract
1. Introduction
2. Materials and Methods
2.1. Materials
2.2. Methods
2.2.1. CS Solution
2.2.2. Cassava Silk Solution
2.2.3. CSF-CS Sponge Preparation
2.3. Physical Property Characterization
2.3.1. Fourier Transform Infrared Spectroscopy (FTIR)
2.3.2. X-ray Diffraction (XRD)
2.3.3. Scanning Electron Microscope (SEM)
2.3.4. Thermal Properties
2.3.5. Porosity
2.3.6. Swelling Rate
2.3.7. Mechanical Properties
2.3.8. Enzymatic Degradation Properties
2.4. Bacteriostatic and Drug Release
2.4.1. Drug Release
2.4.2. Antibacterial Tests
3. Results and Analysis
3.1. Physical Properties
3.1.1. Chemical Characterization of the Composite Sponges
3.1.2. Scanning Electron Microscopy Observation (SEM)
3.1.3. Thermogravimetric Analysis
3.1.4. Porosity and Swelling Rate
3.1.5. Mechanical Strength and Enzymatic Degradation Rate
3.2. Bacterial Inhibition Rate and Drug Release
3.2.1. Drug Release
3.2.2. Antibacterial Tests: Inhibitory Bacteria Tests
4. Conclusions
Author Contributions
Funding
Institutional Review Board Statement
Informed Consent Statement
Data Availability Statement
Conflicts of Interest
References
- Verlee, A.; Mincke, S.; Stevens, C.V. Recent developments in antibacterial and antifungal chitosan and its derivatives. Carbohydr. Polym. 2017, 164, 268–283. [Google Scholar] [CrossRef] [PubMed]
- Zhang, X.; Reagan, M.R.; Kaplan, D.L. Electrospun silk biomaterial scaffolds for regenerative medicine. Adv. Drug Deliv. Rev. 2009, 61, 988–1006. [Google Scholar] [CrossRef] [PubMed]
- Aznar-Cervantes, S.D.; Pagan, A.; Monteagudo Santesteban, B.; Cenis, J.L. Effect of different cocoon stifling methods on the properties of silk fibroin biomaterials. Sci. Rep. 2019, 9, 6703. [Google Scholar] [CrossRef] [PubMed]
- Holland, C.; Numata, K.; Rnjak-Kovacina, J.; Seib, F.P. The Biomedical Use of Silk: Past, Present, Future. Adv. Healthc. Mater. 2019, 8, e1800465. [Google Scholar] [CrossRef] [PubMed]
- Nguyen, T.P.; Nguyen, Q.V.; Nguyen, V.-H.; Le, T.-H.; Huynh, V.Q.N.; Vo, D.-V.N.; Trinh, Q.T.; Kim, S.Y.; Le, Q.V. Silk Fibroin-Based Biomaterials for Biomedical Applications: A Review. Polymers 2019, 11, 1933. [Google Scholar] [CrossRef] [PubMed]
- Omenetto, F.G.; Kaplan, D.L. New Opportunities for an Ancient Material. Science 2010, 329, 528–531. [Google Scholar] [CrossRef] [PubMed]
- Naseri-Nosar, M.; Ziora, Z.M. Wound dressings from naturally-occurring polymers: A review on homopolysaccharide-based composites. Carbohydr. Polym. 2018, 189, 379–398. [Google Scholar] [CrossRef] [PubMed]
- Alven, S.; Adeyemi, S.A.; Ubanako, P.; Ndinteh, D.T.; Choonara, Y.E.; Aderibigbe, B.A. Efficacy of co-loading Ag nanoparticles and metronidazole in PEG-gelatin-based sponges for the treatment of chronic wounds. Polym. Bull. 2023, 81, 4819–4849. [Google Scholar] [CrossRef]
- Liang, Y.; Zhao, X.; Ma, P.X.; Guo, B.; Du, Y.; Han, X. pH-responsive injectable hydrogels with mucosal adhesiveness based on chitosan-grafted-dihydrocaffeic acid and oxidized pullulan for localized drug delivery. J. Colloid Interface Sci. 2019, 536, 224–234. [Google Scholar] [CrossRef]
- Leppiniemi, J.; Lahtinen, P.; Paajanen, A.; Mahlberg, R.; Metsä-Kortelainen, S.; Pinomaa, T.; Pajari, H.; Vikholm-Lundin, I.; Pursula, P.; Hytönen, V.P. 3D-Printable Bioactivated Nanocellulose–Alginate Hydrogels. ACS Appl. Mater. Interfaces 2017, 9, 21959–21970. [Google Scholar] [CrossRef]
- Nakazawa, Y.; Bamba, M.; Nishio, S.; Asakura, T. Tightly winding structure of sequential model peptide for repeated helical region in Samia cynthia ricini silk fibroin studied with solid-state NMR. Protein Sci. 2003, 12, 666–671. [Google Scholar] [CrossRef]
- Pal, S.; Kundu, J.; Talukdar, S.; Thomas, T.; Kundu, S.C. An emerging functional natural silk biomaterial from the only domesticated non-mulberry silkworm Samia ricini. Macromol. Biosci. 2013, 13, 1020–1035. [Google Scholar] [CrossRef] [PubMed]
- Ishida, M.; Asakura, T.; Yokoi, M.; Saito, H. Solvent-and mechanical-treatment-induced conformational transition of silk fibroins studies by high-resolution solid-state carbon-13 NMR spectroscopy. Macromolecules 1990, 23, 88–94. [Google Scholar] [CrossRef]
- Nakazawa, Y.; Asakura, T. Heterogeneous exchange behavior of Samia cynthia ricini silk fibroin during helix–coil transition studied with 13C NMR. FEBS Lett. 2002, 529, 188–192. [Google Scholar] [CrossRef] [PubMed]
- Wang, F.; Wolf, N.; Rocks, E.-M.; Vuong, T.; Hu, X. Comparative studies of regenerated water-based Mori, Thai, Eri, Muga and Tussah silk fibroin films. J. Therm. Anal. Calorim. 2015, 122, 1069–1076. [Google Scholar] [CrossRef]
- Zhao, S.; Ma, P.; Wan, A.; Huang, J.; Yu, H.; Lai, E.; Lin, H.; Miao, X.; Yue, X. The Fabrication of Cassava Silk Fibroin-Based Composite Film with Graphene Oxide and Chitosan Quaternary Ammonium Salt as a Biodegradable Membrane Material. Autex Res. J. 2020, 21, 459–466. [Google Scholar] [CrossRef]
- Silva, S.S.; Oliveira, N.M.; Oliveira, M.B.; da Costa, D.P.S.; Naskar, D.; Mano, J.F.; Kundu, S.C.; Reis, R.L. Fabrication and characterization of Eri silk fibers-based sponges for biomedical application. Acta Biomater. 2016, 32, 178–189. [Google Scholar] [CrossRef] [PubMed]
- Bhardwaj, N.; Rajkhowa, R.; Wang, X.; Devi, D. Milled non-mulberry silk fibroin microparticles as biomaterial for biomedical applications. Int. J. Biol. Macromol. 2015, 81, 31–40. [Google Scholar] [CrossRef] [PubMed]
- Chouhan, D.; Chakraborty, B.; Nandi, S.K.; Mandal, B.B. Role of non-mulberry silk fibroin in deposition and regulation of extracellular matrix towards accelerated wound healing. Acta Biomater. 2017, 48, 157–174. [Google Scholar] [CrossRef]
- Singh, Y.P.; Bandyopadhyay, A.; Mandal, B.B. 3D Bioprinting Using Cross-Linker-Free Silk–Gelatin Bioink for Cartilage Tissue Engineering. ACS Appl. Mater. Interfaces 2019, 11, 33684–33696. [Google Scholar] [CrossRef]
- Naskar, D.; Sapru, S.; Ghosh, A.K.; Reis, R.L.; Dey, T.; Kundu, S.C. Nonmulberry silk proteins: Multipurpose ingredient in bio-functional assembly. Biomed. Mater. 2021, 16, 062002. [Google Scholar] [CrossRef] [PubMed]
- Janani, G.; Kumar, M.; Chouhan, D.; Moses, J.C.; Gangrade, A.; Bhattacharjee, S.; Mandal, B.B. Insight into Silk-Based Biomaterials: From Physicochemical Attributes to Recent Biomedical Applications. ACS Appl. Bio Mater. 2019, 2, 5460–5491. [Google Scholar] [CrossRef] [PubMed]
- Sezutsu, H.; Yukuhiro, K. The complete nucleotide sequence of the Eri-silkworm (Samia cynthia ricini) fibroin gene. J. Insect Biotechnol. Sericology 2014, 83, 3_059–053_070. [Google Scholar]
- Zou, S.; Yao, X.; Shao, H.; Reis, R.L.; Kundu, S.C.; Zhang, Y. Nonmulberry silk fibroin-based biomaterials: Impact on cell behavior regulation and tissue regeneration. Acta Biomater. 2022, 153, 68–84. [Google Scholar] [CrossRef] [PubMed]
- Hemmingsen, L.M.; Julin, K.; Ahsan, L.; Basnet, P.; Johannessen, M.; Škalko-Basnet, N. Chitosomes-in-chitosan hydrogel for acute skin injuries: Prevention and infection control. Mar. Drugs 2021, 19, 269. [Google Scholar] [CrossRef]
- Aguilar, A.; Zein, N.; Harmouch, E.; Hafdi, B.; Bornert, F.; Offner, D.; Clauss, F.; Fioretti, F.; Huck, O.; Benkirane-Jessel, N. Application of chitosan in bone and dental engineering. Molecules 2019, 24, 3009. [Google Scholar] [CrossRef]
- Islam, S.; Arnold, L.; Padhye, R. Comparison and Characterisation of Regenerated Chitosan from 1-Butyl-3-methylimidazolium Chloride and Chitosan from Crab Shells. BioMed Res. Int. 2015, 10, 874316. [Google Scholar] [CrossRef] [PubMed]
- Kou, S.G.; Peters, L.M.; Mucalo, M.R. Chitosan: A review of sources and preparation methods. Int. J. Biol. Macromol. 2021, 169, 85–94. [Google Scholar] [CrossRef] [PubMed]
- Wang, W.; Meng, Q.; Li, Q.; Liu, J.; Zhou, M.; Jin, Z.; Zhao, K. Chitosan derivatives and their application in biomedicine. Int. J. Mol. Sci. 2020, 21, 487. [Google Scholar] [CrossRef]
- Anisha, B.S.; Biswas, R.; Chennazhi, K.P.; Jayakumar, R. Chitosan–hyaluronic acid/nano silver composite sponges for drug resistant bacteria infected diabetic wounds. Int. J. Biol. Macromol. 2013, 62, 310–320. [Google Scholar] [CrossRef]
- Liu, W.; Yang, C.; Gao, R.; Zhang, C.; Ou-Yang, W.; Feng, Z.; Zhang, C.; Pan, X.; Huang, P.; Kong, D.; et al. Polymer Composite Sponges with Inherent Antibacterial, Hemostatic, Inflammation-Modulating and Proregenerative Performances for Methicillin-Resistant Staphylococcus aureus-Infected Wound Healing. Adv. Healthc. Mater. 2021, 10, 2101247. [Google Scholar] [CrossRef] [PubMed]
- Liu, R.; Xi, P.; Yang, N.; Luo, Y.; Cheng, B. Chitosan/poly (ethylene oxide) nanofiber sponge with dual-responsive drug release and excellent antibacterial property. Int. J. Biol. Macromol. 2023, 246, 125731. [Google Scholar] [CrossRef] [PubMed]
- Xu, Z.; Chen, T.; Zhang, K.Q.; Meng, K.; Zhao, H. Silk fibroin/chitosan hydrogel with antibacterial, hemostatic and sustained drug-release activities. Polym. Int. 2021, 70, 1741–1751. [Google Scholar] [CrossRef]
- Hu, X.; Kaplan, D.; Cebe, P. Determining beta-sheet crystallinity in fibrous proteins by thermal analysis and infrared spectroscopy. Macromolecules 2006, 39, 6161–6170. [Google Scholar] [CrossRef]
- Yang, Y.Y.; Lv, Z.N.; Tian, W.; Zhu, C.Y. Structure and properties of cassava silk. J. Text. Res. 2017, 38, 1–5. [Google Scholar]
- Zhou, W.; Chen, X.; Shao, Z. Conformation Studies of Silk Proteins with Infrared and Raman Spectroscopy. Prog. Chem. 2006, 18, 1514–1522. [Google Scholar]
- Chen, X.; Li, W.; Yu, T. Conformation transition of silk fibroin induced by blending chitosan. J. Polym. Sci. Part B Polym. Phys. 1997, 35, 2293–2296. [Google Scholar] [CrossRef]
- Li, M.; Tao, W.; Kuga, S.; Nishiyama, Y. Controlling molecular conformation of regenerated wild silk fibroin by aqueous ethanol treatment. Polym. Adv. Technol. 2003, 14, 694–698. [Google Scholar] [CrossRef]
- Minoura, N.; Aiba, S.I.; Higuchi, M.; Gotoh, Y.; Tsukada, M.; Imai, Y. Attachment and Growth of Fibroblast Cells on Silk Fibroin. Biochem. Biophys. Res. Commun. 1995, 208, 511–516. [Google Scholar] [CrossRef]
- Xu, M.; Zuo, B.Q. Study on the Structure of Electrospun Fibers from Regenerated Samia Cynthia Ricini Silk Fibroin. Silk 2008, 3, 16–18+39. [Google Scholar]
- Bao, W.; Li, M.; Yang, Y.; Wan, Y.; Wang, X.; Bi, N.; Li, C. Advancements and frontiers in the high performance of natural hydrogels for cartilage tissue engineering. Front. Chem. 2020, 8, 53. [Google Scholar] [CrossRef] [PubMed]
- Puppi, D.; Chiellini, F.; Piras, A.M.; Chiellini, E. Polymeric materials for bone and cartilage repair. Prog. Polym. Sci. 2010, 35, 403–440. [Google Scholar] [CrossRef]
- Volpi, M.; Paradiso, A.; Costantini, M.; Świȩszkowski, W. Hydrogel-based fiber biofabrication techniques for skeletal muscle tissue engineering. ACS Biomater. Sci. Eng. 2022, 8, 379–405. [Google Scholar] [CrossRef] [PubMed]

| Sample | Mean Pore Size (μm) | Porosity (%) |
|---|---|---|
| CSF | 126.2 ± 9.6 | 60.5 ± 4.2 |
| CSF-CS20% | 85.1 ± 13.7 | 71.2 ± 3.7 |
| CSF-CS40% | 81.9 ± 5.3 | 83.0 ± 2.4 |
| CSF-CS60% | 60.2 ± 5.9 | 84.7 ± 5.6 |
Disclaimer/Publisher’s Note: The statements, opinions and data contained in all publications are solely those of the individual author(s) and contributor(s) and not of MDPI and/or the editor(s). MDPI and/or the editor(s) disclaim responsibility for any injury to people or property resulting from any ideas, methods, instructions or products referred to in the content. |
© 2024 by the authors. Licensee MDPI, Basel, Switzerland. This article is an open access article distributed under the terms and conditions of the Creative Commons Attribution (CC BY) license (https://creativecommons.org/licenses/by/4.0/).
Share and Cite
Chen, Y.; Lin, H.; Yue, X.; Lai, E.; Huang, J.; Zhao, Z. Wound Dressing Based on Cassava Silk-Chitosan. Materials 2024, 17, 2986. https://doi.org/10.3390/ma17122986
Chen Y, Lin H, Yue X, Lai E, Huang J, Zhao Z. Wound Dressing Based on Cassava Silk-Chitosan. Materials. 2024; 17(12):2986. https://doi.org/10.3390/ma17122986
Chicago/Turabian StyleChen, Yumei, Haitao Lin, Xinxia Yue, Enping Lai, Jiwei Huang, and Ziyu Zhao. 2024. "Wound Dressing Based on Cassava Silk-Chitosan" Materials 17, no. 12: 2986. https://doi.org/10.3390/ma17122986
APA StyleChen, Y., Lin, H., Yue, X., Lai, E., Huang, J., & Zhao, Z. (2024). Wound Dressing Based on Cassava Silk-Chitosan. Materials, 17(12), 2986. https://doi.org/10.3390/ma17122986
